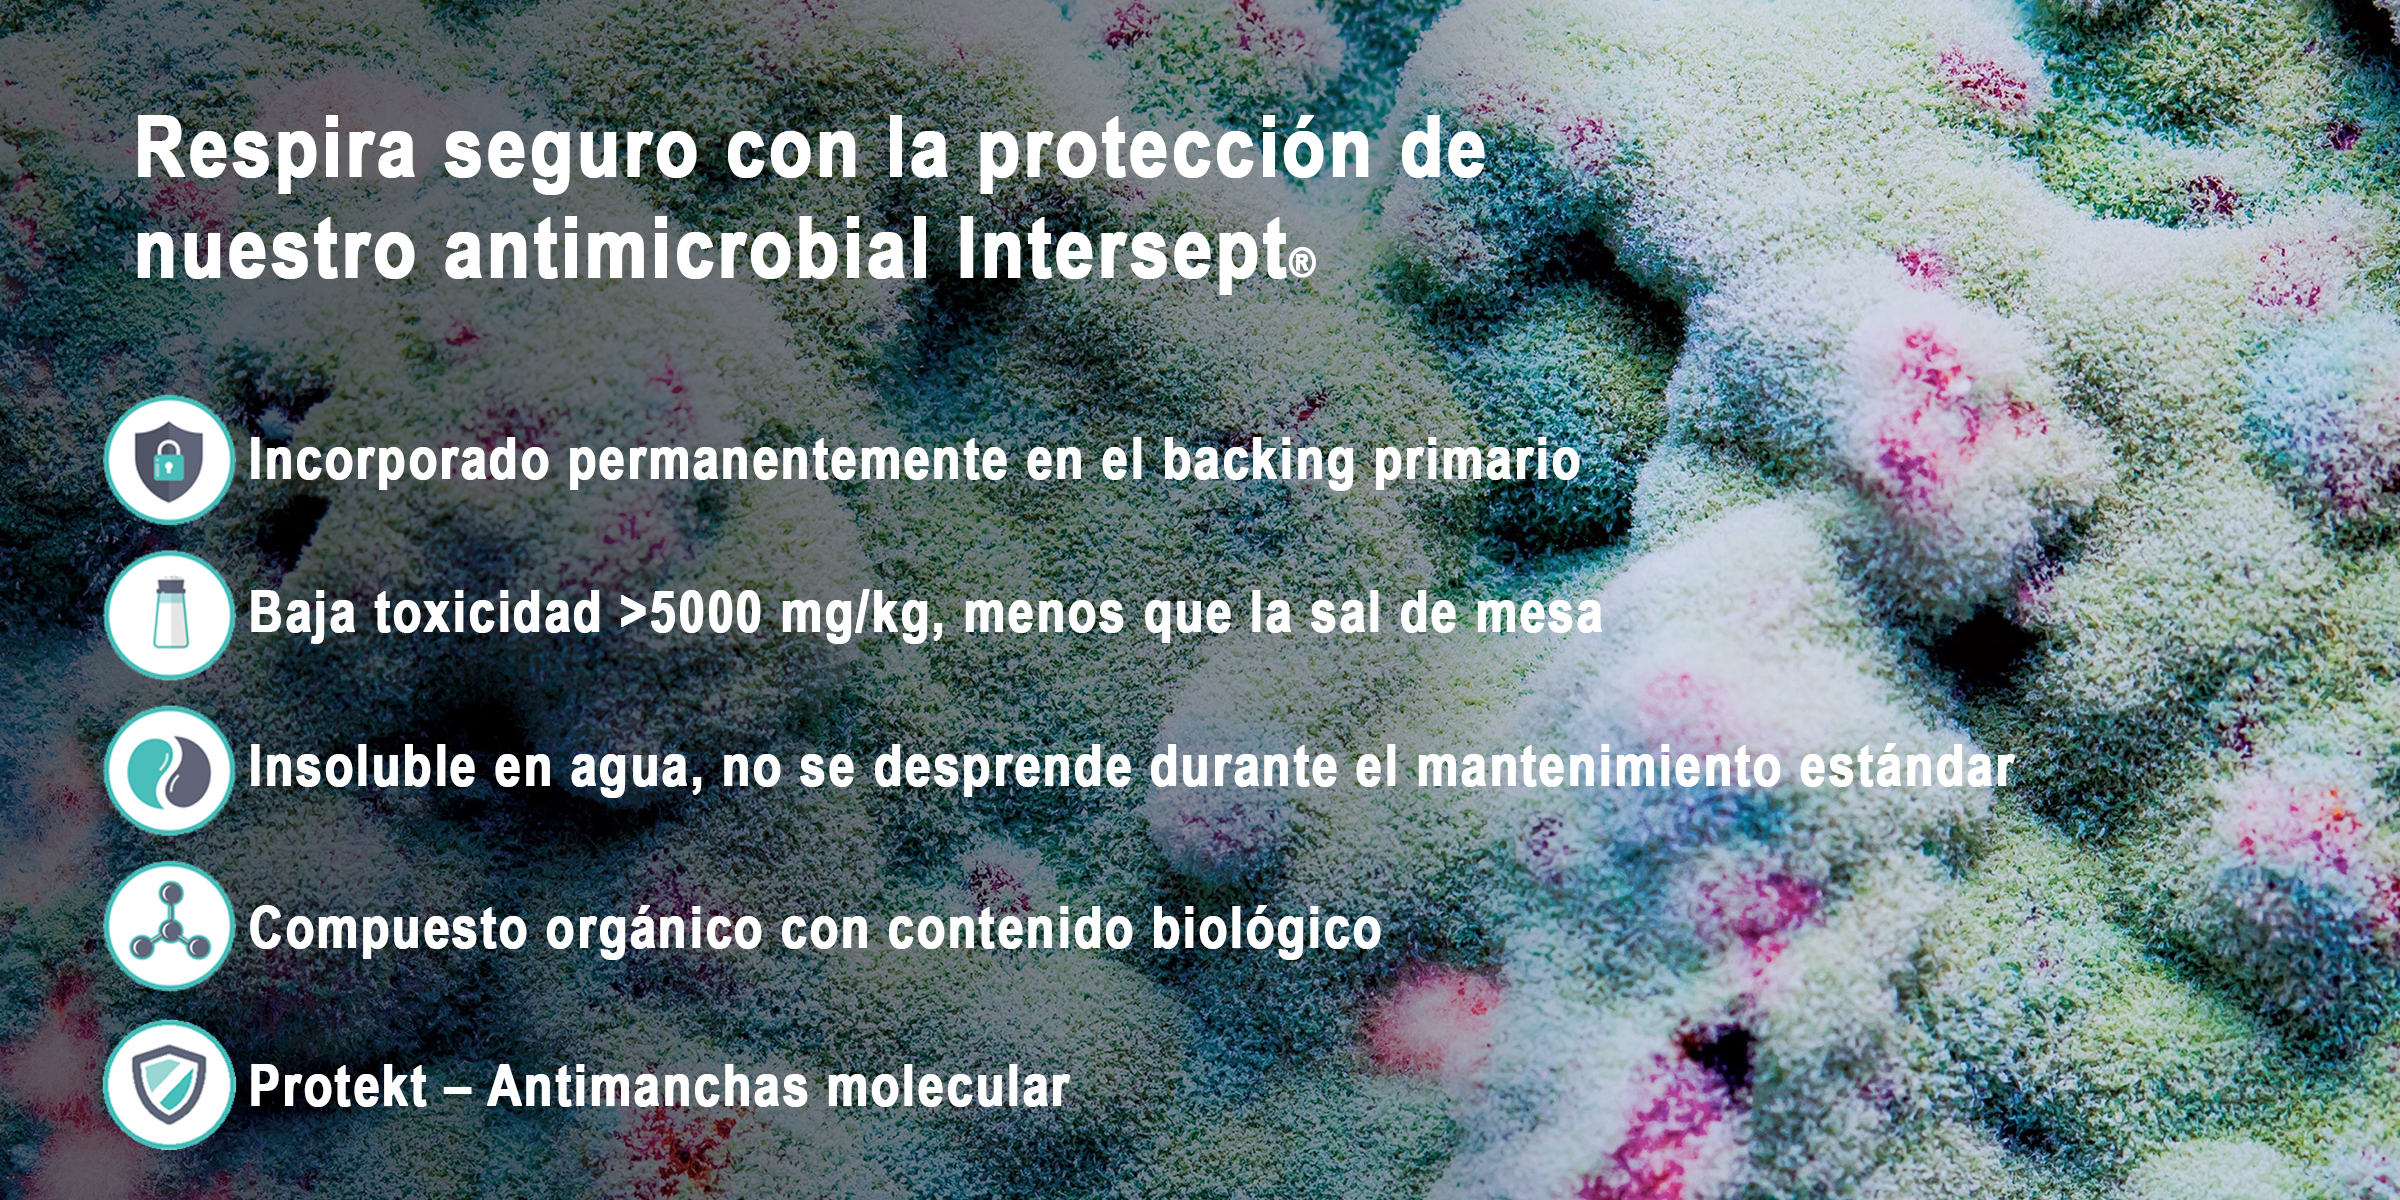

Soluciones Interface para distintos
tipos de espacios
Espacios de trabajo
• Oficinas abiertas, privadas y áreas operativas
• Salas de juntas y espacios colaborativos
• Recepciones, pasillos y áreas de transición
• Salas de juntas y espacios colaborativos
• Recepciones, pasillos y áreas de transición

Salud
• Hospitales
• Laboratorios
• Salas de terapia, rehabilitación y bienestar
• Laboratorios
• Salas de terapia, rehabilitación y bienestar

Hospitalidad
• Hoteles
• Restaurantes y cafeterías
• Áreas recreativas y de esparcimiento
• Restaurantes y cafeterías
• Áreas recreativas y de esparcimiento

Educación
• Escuelas
• Universidades
• Bibliotecas y centros de capacitación
• Universidades
• Bibliotecas y centros de capacitación

Retail
• Centros comerciales
• Tiendas departamentales
• Showrooms
• Tiendas departamentales
• Showrooms

Aeropuertos
• Salas de espera
• Salas VIP
• Corredores, pasillos y zonas de abordaje
• Salas VIP
• Corredores, pasillos y zonas de abordaje


Beneficios que elevan
la experiencia de tus espacios
con Interface
Confort acústico
Las alfombras modulares de Interface reducen el ruido y mejoran la calidad sonora de los espacios, creando ambientes más cómodos y agradables de habitar y disfrutar. Su construcción textil absorbe el sonido de impacto y disminuye la reverberación, favoreciendo la concentración, la privacidad y el bienestar en cualquier entorno.


Diseño modular y flexible
Gracias a sus formatos 50x50cm, 25x100cm, 50x100cm y 100x100cm, es posible combinar colores, texturas y patrones para zonificar, crear recorridos o aportar identidad a un espacio de manera sencilla y sin complicar la instalación. Además, su sistema modular permite un mantenimiento altamente eficiente: si una loseta se daña, solo se reemplaza esa pieza, reduciendo costos, tiempos y facilitando el mantenimiento a largo plazo.
Durabilidad y desempeño
Sus materiales ofrecen alta resistencia al desgaste y un ciclo de vida más largo, ideales para espacios de tráfico intenso. Las losetas están diseñadas para soportar uso continuo sin deformarse, gracias a sus backings de alto desempeño y a sus fibras teñidas en solución (solution dyed), donde el color se incorpora desde la fabricación dentro de la propia fibra, evitando que se desgaste o se desvanezca con la limpieza o el uso. Esto garantiza un rendimiento óptimo incluso en áreas de alta circulación.


Enfoque en sostenibilidad
Muchas colecciones incluyen contenido reciclado y tecnologías enfocadas en reducir la huella ambiental, sin comprometer desempeño ni estética.
Interface es pionera en sostenibilidad dentro de la industria, ofreciendo pisos 100% carbono neutral durante todo su ciclo de vida. Además, impulsa prácticas de economía circular mediante materiales reciclados, procesos de fabricación eficientes y programas de recuperación de alfombras, contribuyendo a proyectos con certificaciones ambientales.
Interface es pionera en sostenibilidad dentro de la industria, ofreciendo pisos 100% carbono neutral durante todo su ciclo de vida. Además, impulsa prácticas de economía circular mediante materiales reciclados, procesos de fabricación eficientes y programas de recuperación de alfombras, contribuyendo a proyectos con certificaciones ambientales.



Tecnología de productos Interface
Tecnología de productos Interface
i2®
Interface es la única marca en el mercado con tecnología i2® la cual es un sistema que elimina los problemas de variación entre lotes de teñido, permitiendo que las losetas se integren entre sí sin importar la fecha de fabricación. Gracias a esto, no existen “parches” visibles en el piso y se reduce de manera significativa el desperdicio durante la instalación.

Fibra 100% Solution Dyed
Las alfombras de Interface están fabricadas con fibras 100% teñidas en solución, lo que garantiza colores más estables, resistentes al desgaste, a la luz y al uso intensivo. Esta tecnología también contribuye a la sostenibilidad, ya que Interface fue pionera en el uso de nylon 100% reciclado, y sus sistemas de corte ultrasónico reducen el desperdicio en más del 80%.

Intersept®
Intersept® es un tratamiento antimicrobiano exclusivo de Interface que protege la alfombra contra bacterias, moho y alérgenos residuales, asegurando un ambiente más saludable. Esta tecnología contribuye a mantener la mejor calidad de aire interior y está respaldada por un rendimiento garantizado durante 15 años.
TacTiles®
TacTiles® es un sistema de instalación libre de adhesivos que permite colocar las alfombras modulares sin pegamentos tradicionales. Esto facilita reemplazar piezas de manera simple y limpia, mejora la calidad del aire interior, reduce el impacto ambiental y permite desmontajes o cambios sin dañar la superficie original.

Carbon Neutral Floors®
Todos los productos de Interface son 100% carbón neutral, lo que significa que su huella de carbono —desde la fabricación hasta la instalación— es completamente compensada. Con este compromiso, Interface se posiciona como líder mundial en sostenibilidad, ayudando a crear espacios responsables sin sacrificar diseño ni rendimiento.

15 años de garantía
Los productos de Interface están respaldados por una garantía de 15 años, que cubre desempeño, estabilidad dimensional, apariencia y durabilidad. Esta garantía refleja la calidad de los materiales, la ingeniería detrás de sus sistemas y la confianza que la marca ofrece en cada instalación.


Acústica
Cuando el sonido impacta un material, pueden ocurrir tres cosas:

Comparativa:

Certificación Quiet Mark
¿Qué mide?
IIC -Impact Insulation Class-
(Clase de Aislamiento de Impacto)
Mientras más alto sea el número, menor es la cantidad de ruido transmitido a través de la estructura.
IIC -Impact Insulation Class-
(Clase de Aislamiento de Impacto)
Mientras más alto sea el número, menor es la cantidad de ruido transmitido a través de la estructura.

Certificaciones de nuestra alfombra

Certificaciones de nuestro LVT

- Beneficios que se sienten desde el primer paso -





















